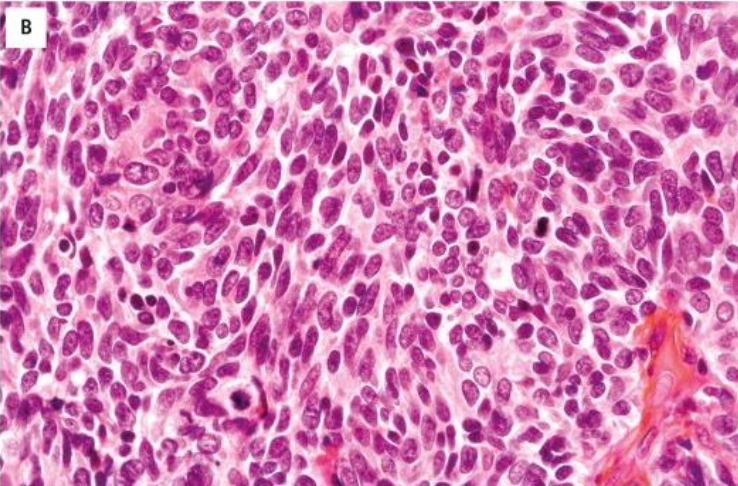
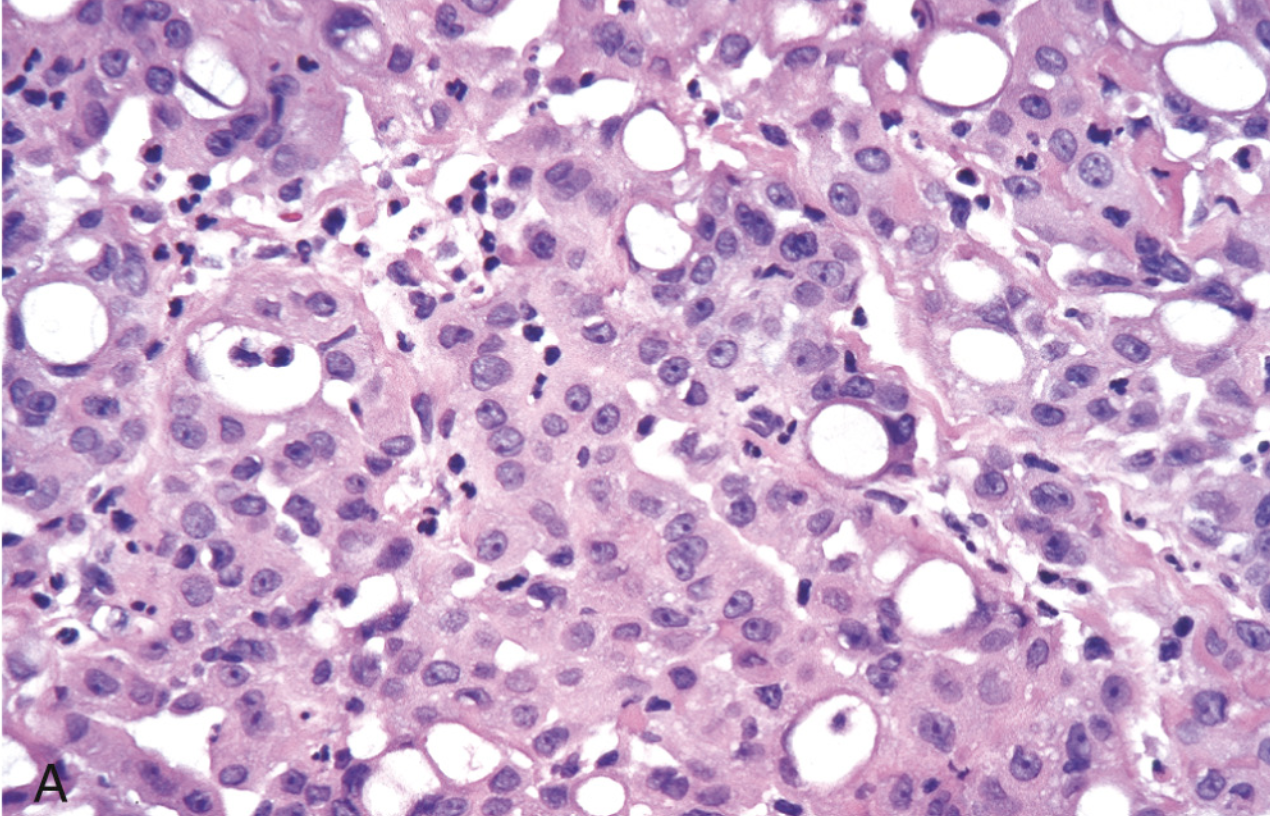
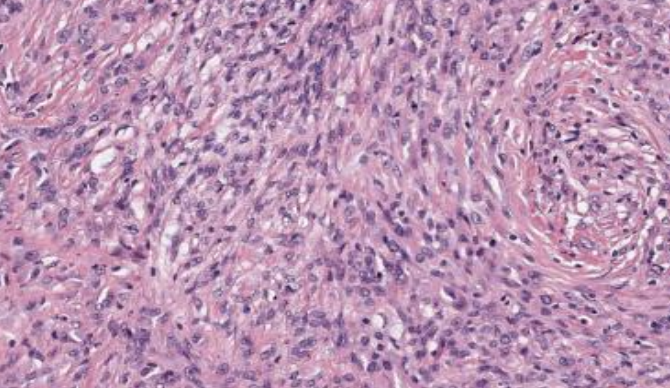

Neoplasias de pulmón
1/50
There's no tags or description
Looks like no tags are added yet.
Name | Mastery | Learn | Test | Matching | Spaced |
|---|
No study sessions yet.
51 Terms
Alrededor del … de los cánceres de pulmón ocurren en fumadores activos o en aquellos que dejaron de fumar recientemente
80%
Tipo de cáncer de pulmón y de mutación en no fumadores
Adenocarcinomas, mutaciones de EGFR
Cuáles son los carcinomas de Células No Pequeñas (NSCLC)
Adenocarcinoma
Carcinoma de cél escamosas (epidermoide)
Carcinoma de cél grandes
Carcinomas de Células Pequeñas (SCLC)
Células neuroendocrinas del pulmón, asociado a fumar
Lesiones precursoras
Displasia escamosa y carcinoma in situ
Hiperplasia adenomatosa atípica
Adenocarcinoma in situ
Hiperplasia difusa idiopática de células neuroendocrinas pulmonares

Hiperplasia adenomatosa atípica
Mide menos de 5mm
Neumocitos displásicos
Pared alveolar ligeramente fibrótica
Paredes se engrosan

Adenocarcinoma in situ
Mide < 3cm
Cél displásicas de alto grado a lo largo de los septos alveolares

Hiperplasia difusa idiopática de células neuroendocrinas pulmonares
Crecimiento nodular < 3mm
Núcleos en sal y pimienta en zona basal

Displasia escamosa y carcinoma in situ
Displasia severa del espesor de la pared epitelial
Mitosis en todos los niveles
Pérdida completa de maduración
Sin invasión
¿Dónde se tienden a ubicar los adenocarcinomas?
Periféricamente
Qué factor expresan la mayoría de los adenocarcinomas
Factor de transcripción tiroidea-1 (TTF-1)

Adenocarcinoma
Tumor lobulado e irrecular, asociado a una cicatriz
Gris-blanquecino

Patrón de adenocarcinoma
Lepídico, reviste la superficie de paredes alveolares, preservando arquitectura pulmonar

Patrón de adenocarcinoma
Patrón lepídico mucinoso

Patrón de adenocarcinoma
Tubular

Patrón de adenocarcinoma
Papilar

Patrón de adenocarcinoma
Micropapilar

Patrón de adenocarcinoma
Sólido mucicarmin
Carcinoma epidermoide muestra presencia de
queratinización o puentes intercelulares
¿Dónde predomina el carcinoma de células escamosas?
Lóbulos superiores, en la periferia porque está asociado a fumar
Característica en cuanto al crecimiento de carcinoma de células escamosas
Crecimiento central exofítico endobronquial
Característica morfológica macroscópica de los carcinomas de células escamosas
Tumores grandes con hemorragia y necrosis

Carcinoma de células escamosas

Citología pulmonar
Carcinoma escamoso queratinizado de pulmón

Carcinoma de células escamosas, nivel de diferenciación
Pobremente diferenciado

Carcinoma de células escamosas, nivel de diferenciación
Moderadamente diferenciado

Carcinoma de células escamosas, nivel de diferenciación
Bien diferenciado
Carcinoma que solo el 1% se presenta en no fumadores
Carcinoma de células pequeñas del pulmón, (neuroendócrino)

Carcinoma de células pequeñas, dónde pueden surgir los tumores
En bronquios principales o en periferia del pulmón

Carcinoma de células pequeñas, características celulares
Células pequeñas redondas, ovaladas o fusiformes
Moldeamiento nuclear
Bordes celulares mla definidos
Carcinoma de células pequeñas, características celulares
Patrón sal y pimienta
Nucleolo ausente
Conteo mitotico alto

EFECTO DE AZZOPARDI
Tinción basofílica de las paredes vasculares debido a acumulación de ADN de núcleos necróticos

Carcinoma de células grandes, microscopia
Núcleos grandes
Nucleolos prominentes
Moderada cantidad de citoplasma
Carcinoma de células grandes, macroscopia
Tumores grandes con necrosis y hemorragia

Carcinoma de células gigantes
Sitios de metastasis carcinoma pulmonar
Glándulas suprarrenales
Hígado
Cerebro
Huesos

Características de tumores carcinoides centrales
Digitiformes o polipoides en luz bronquial revestidos por mucosa normal
< 4mm
Bronquios principales
Lesión en botón de cuello de camisa, cuando penetran tejido peribronquial
Características de tumores carcinoides periféricos
Sólidos y nodulares

Tumores carcinoides microscopicamente
Células organoides (nidos)
Separados por estroma fibrovascular delicado
Células regulares
Núcleos redondos uniformes
Tumor carcinoide típico

<2 mitosis x 10 HPF, no necrosis
Tumor carcinoide atípico

2-10 mitosis x 10 HPF
Células más grandes
Pleomórficas con nucléolo prominente
Focos de necrosis

¿Qué es?
Tumor metastasico
Tumores metastásicos características
Patrón de crecimiento variable
Múltiples nódulos solitarios

Tumor metastásico
¿Qué es el mesotelioma?
Neoplasia maligna de origen pleural altamente agresivo

Mesotelioma morfología
Tumor blando, gelatinoso, color rosa grisáceo
Mesotelioma mutación
Deleción homocigótica del cromosoma 9p, gen supresor tumoral CDKN2A
Tipos de mesotelomia
Epiteloide
Sarcomatoide
Mixto
Mesotelioma epiteloide
Parece adenocarcinoma: diferenciador
Calretinina, WT-1 CK5/6 positivos

Mesotelomia mixto, qué son las células oscuras
La parte epiteloide
Patrón sarcomatoide
Positivo a veces para citoqueratina